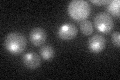
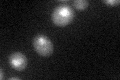
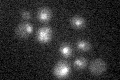

View description
DNA binding component of the SBF complex (Swi4p-Swi6p), a transcriptional activator that in concert with MBF (Mbp1-Swi6p) regulates late G1-specific transcription of targets including cyclins and genes required for DNA synthesis and repair
Localization:
Intensity:
Fold change:
Significance:
-
C’ GFP library in SD
nucleus22.32 -
N' NOP1pr-GFP in SD

nucleus34.8973 -
N' TEF2pr-mCherry in SD

nucleus11.2339 -
N' NATIVEpr-GFP in SD

nucleus26.917 -
N' TEF2pr-VC and Cyto-VN in SD

below threshold23.3552 -
C’ GFP library in SD+DTT
nucleus22.080.98No -
C’ GFP library in SD+H2O2

nucleus24.061.07No -
C’ GFP library in Starvation Media
nucleus18.470.82No -
C’ GFP library on the background of Pup2-DaMP

nucleus -
C’ GFP library on the background of CCT mutant

nucleus24.47241.09612No
